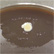
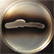

わたしたちの使命
生物遺伝資源の提供、遺伝子組換え技術の産業利用における安全確保、生物遺伝資源利用のための国際的ネットワーク構築などバイオ産業の発展を支援しています。
2030年の目指すべきビジョンを作成しました(ビジョンのページを表示)。
重要なお知らせ重要なお知らせ 過去の一覧
- 2026年6月9日
- 【ニュースリリース】プラスチックの海洋生分解度試験方法の再現性向上を目指して
- 2026年4月7日
- 【事業・サービス】GW期間中の発送休止期間(2026年4月24日(金曜日)~2026年5月6日(水曜日))
- 2026年4月6日
- 【ニュースリリース】国内初、特性情報から微生物種を検索できる統合データベースを開発・公開しました
- 2026年3月6日
- 【事業・サービス】NBRCオンラインカタログの一時停止について(2026年3月25日(水曜日)、2026年3月31日(火曜日)~2026年4月1日(水曜日))
- 2026年2月12日
- 【ニュースリリース】化学合成独立栄養細菌が持つCO₂固定経路の有無をゲノムから高精度に予測するツール「AutoFixMark」を開発
- 2026年2月5日
- 【事業・サービス】NBRC株等に係る手数料改定のお知らせ(2026年4月1日から)
- 2025年8月7日
- 【事業・サービス】システム障害による分譲依頼受付業務の一時停止のお詫び
- 2025年8月4日
- 竹内経済産業大臣政務官にNBRCをご視察いただきました
- 2025年6月5日
- 【ニュースリリース】NITEが技術協力した世界初の次世代微生物同定ソフトウェアが製品化
~未培養や難培養を含む約8万5千種の原核微生物の迅速同定が可能に~ - 2025年6月4日
- 【事業・サービス】NITEバイオテクノロジーセンターの業務説明会のご案内
お知らせお知らせ 過去の一覧
- 2026年6月1日
- 「NBRCニュース」第99号 菌株選定がもっとラクに!新ツール登場 / 真菌有害情報(Web版)公開
- 2026年5月27日
- 【DBRP】NBRC株およびRD株のデータを更新しました。
- 2026年5月25日
- 【RD株】提供可能なRD株リストを更新しました。
- 2026年5月20日
- 真菌168種のMALDI-TOF MS実測データを新規公開しました。
- 2026年5月13日
- Alicyclobacillus属細菌種(新属Paenalicyclobacillus属細菌種含む)のMALDI-TOF MS微生物同定用ライブラリーを大幅拡張し、全118ライブラリーの提供を開始しました。
- 2026年3月23日
- 「NBRCニュース」第98号 連載「びせいぶつ学習帳:知っているようで知らない微生物の話(7)/プラスチックと微生物(4)/他」
- 2026年2月2日
- 「NBRCニュース」第97号 連載「微生物あれこれ(67)/他」
- 2025年12月25日
- 【動画公開】【NITE講座】講義動画を公開しました。「微生物の同定や解析のための基盤技術 -MALDI-TOF MSを用いた微生物同定と、マイクロバイオーム解析の精度向上-」
- 2025年12月17日
- 【NBRC】ラビリンチュラ類のリストを更新しました。
- 2025年12月11日
- 【ニュースリリース】海洋生分解性プラスチックの微生物による分解を評価、解析するための分析法を開発 -製品の開発や海洋生分解の理解の促進に期待-
業務の案内
資源の種類で選ぶ
用途で選ぶ
 RD株
RD株- 産業開発用途に多様な微生物種を1年単位の貸与でご提供しています
 検定等に規定されている菌
検定等に規定されている菌- JIS、薬局方、ISO等に規定される検定用の菌株をご紹介します
特許に利用された菌
特許に利用された菌- 過去に特許出願に利用された菌株をご紹介します
 食品汚染・住環境等から分離された菌
食品汚染・住環境等から分離された菌- 食品汚染や住環境等から分離された菌株を糸状菌(カビ)を中心にご紹介します
汚染物質等の分解菌
汚染物質等の分解菌- 汚染物質及び類似物質の分解能の研究報告がある菌株をご紹介します
よく利用される情報
- 様式・手引きのダウンロード
- 各種サービスを利用するために必要な様式・手引きはこちら
- 手数料一覧
- 各種サービスにかかる手数料はこちら
- 微生物株の培養と保存
- NBRC株の培養や保存方法、ガラスアンプルの開け方についてご紹介します。
- Q&A
- よくあるご質問をまとめておりますので、サービスをご利用になる際にご参照ください
- お問い合わせ先
- 各種サービスに関するお問い合わせ先はこちら
- イベント出展情報
- イベントに出展されたバイオテクノロジーセンター関連の情報はこちら
お問い合わせ
- 独立行政法人製品評価技術基盤機構 バイオテクノロジーセンター 計画課
-
TEL:03-3481-1933
住所:〒151-0066 東京都渋谷区西原2-49-10 地図
お問い合わせフォームへ








